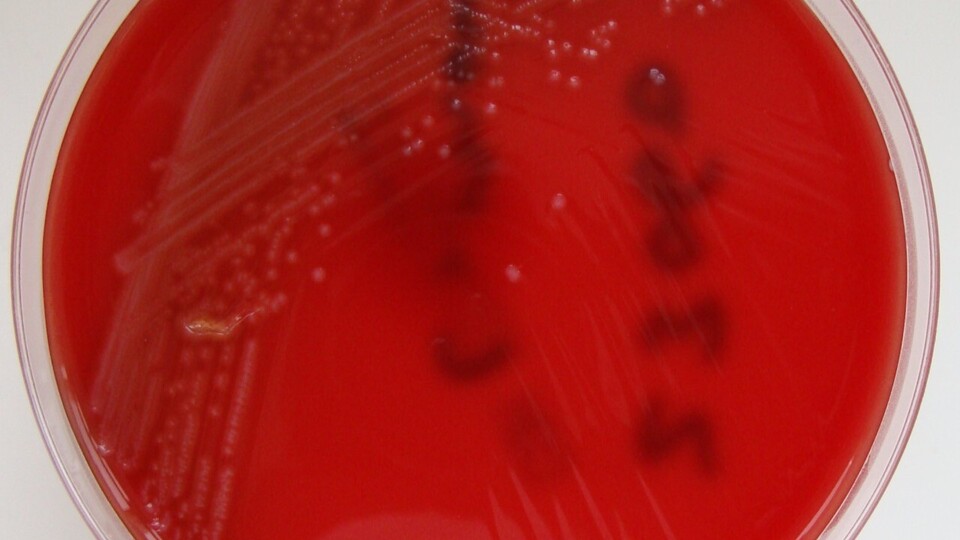

La experta pone en valor las numerosas funciones del farmacéutico adscrito a las administraciones públicas en el ámbito de la salud pública.
Dentro de la profesión farmacéutica es bien conocido el papel que desempeña el farmacéutico comunitario, muy cercano a la población y que presta un servicio de calidad. Sin embargo, no es tan conocido y valorado el rol de los farmacéuticos en los ámbitos de la prevención y protección de la salud adscritos a los Servicios de Salud de las autonomías.
La Ley 44/2003, de Ordenación de Profesiones Sanitarias establece que corresponde a los licenciados en Farmacia las actividades dirigidas a la producción, conservación y dispensación de medicamentos, así como la colaboración en procesos analíticos, farmacoterapéuticos y de vigilancia de la Salud Pública. Dentro del amplio campo de la Salud Pública, estos profesionales son expertos cualificados en el control de riesgos relacionados con la sanidad ambiental y la seguridad alimentaria.En sanidad ambiental realizan funciones como el control de las instalaciones de riesgo en la transmisión de la legionelosis (torres de refrigeración, condensadores evaporativos, sistemas de agua fría y caliente sanitaria…), el control y vigilancia de las aguas potables de consumo humano distribuidas por empresas abastecedoras, de las zonas de aguas de baño, de los riesgos provocados por el uso y comercialización de productos químicos y establecimientos biocidas o de establecimientos y actividades acuáticas (piscinas, centros de ocio…), entre otras. En el campo de la seguridad alimentaria realizan funciones de vigilancia y control de la producción y comercialización de los alimentos, que se llevan a cabo a través de controles oficiales (inspecciones y auditorías) en industrias alimentarias, minoristas de alimentación, mercados, establecimientos de restauración, comedores escolares etc., control del tabaco en establecimientos alimentarios y centros escolares.
Una legislación clara
En estos últimos meses se ha generado una alerta sanitaria por la presencia del microorganismo nocivo (Listeria monocytogenes) en una serie de productos cárnicos comercializados. Tenemos que partir de la base de que la legislación alimentaria deja claro que es el operador económico el responsable de la seguridad alimentaria de los productos que pone en el mercado, aspecto que ya se ha puesto de manifiesto en este brote de listeriosis. Sin embargo, no todas las personas conocen bien las actuaciones que realizan los farmacéuticos en la detección y control de estas situaciones de riesgo inminente y extraordinario para la salud. Amparados por la normativa vigente, y sin entrar en las competencias que sobre el control oficial en determinadas capitales tienen los ayuntamientos, hemos realizado actuaciones de tomas de muestras de productos para su análisis y determinación de listeria, estudios de trazabilidad y de los sistemas de autocontrol implantados en las empresas alimentarias, búsqueda de lotes de productos afectados e inmovilizaciones de los mismos, retirada de productos de la venta y consumo y otras medidas cautelares, que deben estar bajo la supervisión de la autoridad sanitaria.
Representación colegial
Estos profesionales, cuyo trabajo tiene como objetivo la protección de la salud y que los productos puestos a disposición del consumidor sean seguros, están representados en las instituciones colegiales. En concreto, en el Consejo General de COF existe una vocalía especifica de Farmacéuticos Titulares, mientras que en los Consejos Autonómicos y en los provinciales, las vocalías de Farmacéuticos de Administraciones Públicas forman parte de su Junta de Gobierno y tienen como misión la defensa del papel del farmacéutico en salud pública.